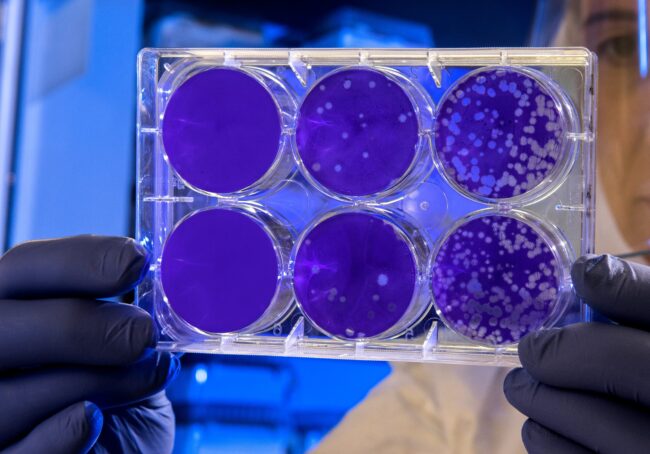

p53-genet og risky spots
Dr. Fran Supek ved Institute for Reaserch in Biomedicine (IRB) i Barcelona leder en forskergruppe som har funnet at genredigering med CPISPR-Cas9 kan føre til giftighet i celler og til ustabile genomer. Slike uønskede konsekvenser oppstår når cellens eget forsvarsgen, p53, aktiveres etter at bruddet i DNA har skjedd. p53-genet kan da registrere den genredigerte…